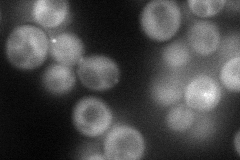
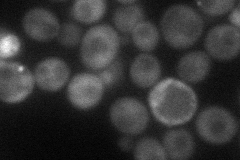
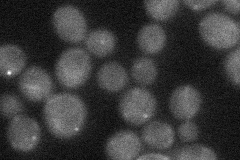
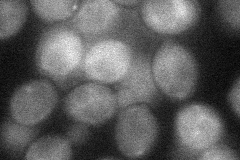
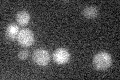

View description
Ser/Thr kinase involved in late nuclear division, one of the mitotic exit network (MEN) proteins; necessary for the execution of cytokinesis
Localization:
Intensity:
Fold change:
Significance:
-
C’ GFP library in SD

below threshold16.02 -
N' NOP1pr-GFP in SD
cytosol,punctate58.5886 -
N' TEF2pr-mCherry in SD
punctate42.9885 -
N' NATIVEpr-GFP in SD
punctate28.8503 -
N' TEF2pr-VC and Cyto-VN in SD
cytosol34.4031 -
C’ GFP library in SD+DTT

cytosol17.031.06No -
C’ GFP library in SD+H2O2

cytosol17.831.11No -
C’ GFP library in Starvation Media
cytosol15.730.98No -
C’ GFP library on the background of Pup2-DaMP

below threshold -
C’ GFP library on the background of CCT mutant

below threshold18.27931.14059No
